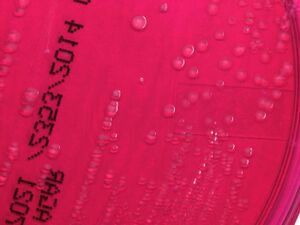

شيغيلة سونية (Q3497245)
نوع من بدائيات النوى
- شيغيلة سيلانية
- شيغيلة متغيرة
- Shigella dispar
- Shigella sonnei
- Shigella ceylonensis
| اللغة | التسمية | الوصف | أسماء أخرى |
|---|---|---|---|
| العربية | شيغيلة سونية |
نوع من بدائيات النوى |
|
| الإنجليزية | Shigella sonnei |
species of bacterium |
بيانات
Wikidata item الإنجليزية
taxon name الإنجليزية
taxon rank الإنجليزية
parent taxon الإنجليزية
instance of الإنجليزية
Gram staining الإنجليزية
MeSH descriptor ID الإنجليزية
Encyclopædia Britannica Online ID الإنجليزية
Commons category الإنجليزية
LPSN URL الإنجليزية
١ مراجع
Imported from Wikidata item الإنجليزية
image الإنجليزية
media legend الإنجليزية
Shigella sonnei creixent en [[agar entèric Hektoen]] (HEK) (الكتالانية)
١ مراجع
Imported from Wikidata item الإنجليزية
CDC 17192 Shigella sonnei XLD.jpg
٧٠٠ × ٥٢٥؛ ٣٠ كيلوبايت
٧٠٠ × ٥٢٥؛ ٣٠ كيلوبايت
١ مراجع
Imported from Wikidata item الإنجليزية
Shigella sonnei in SIM Agar 126.jpg
١٬٤٩٧ × ٣٬٠٠٠؛ ١٫٣ ميجابايت
١٬٤٩٧ × ٣٬٠٠٠؛ ١٫٣ ميجابايت
١ مراجع
Imported from Wikidata item الإنجليزية
named after الإنجليزية
UNII الإنجليزية
Freebase ID الإنجليزية
MeSH tree code الإنجليزية
short name الإنجليزية
وصلات الموقع
Marefa(٠ مدخلة)
ويكيبيديا(٤ مدخلات)
- cawiki Shigella sonnei
- enwiki Shigella sonnei
- eswiki Shigella sonnei
- frwiki Shigella sonnei